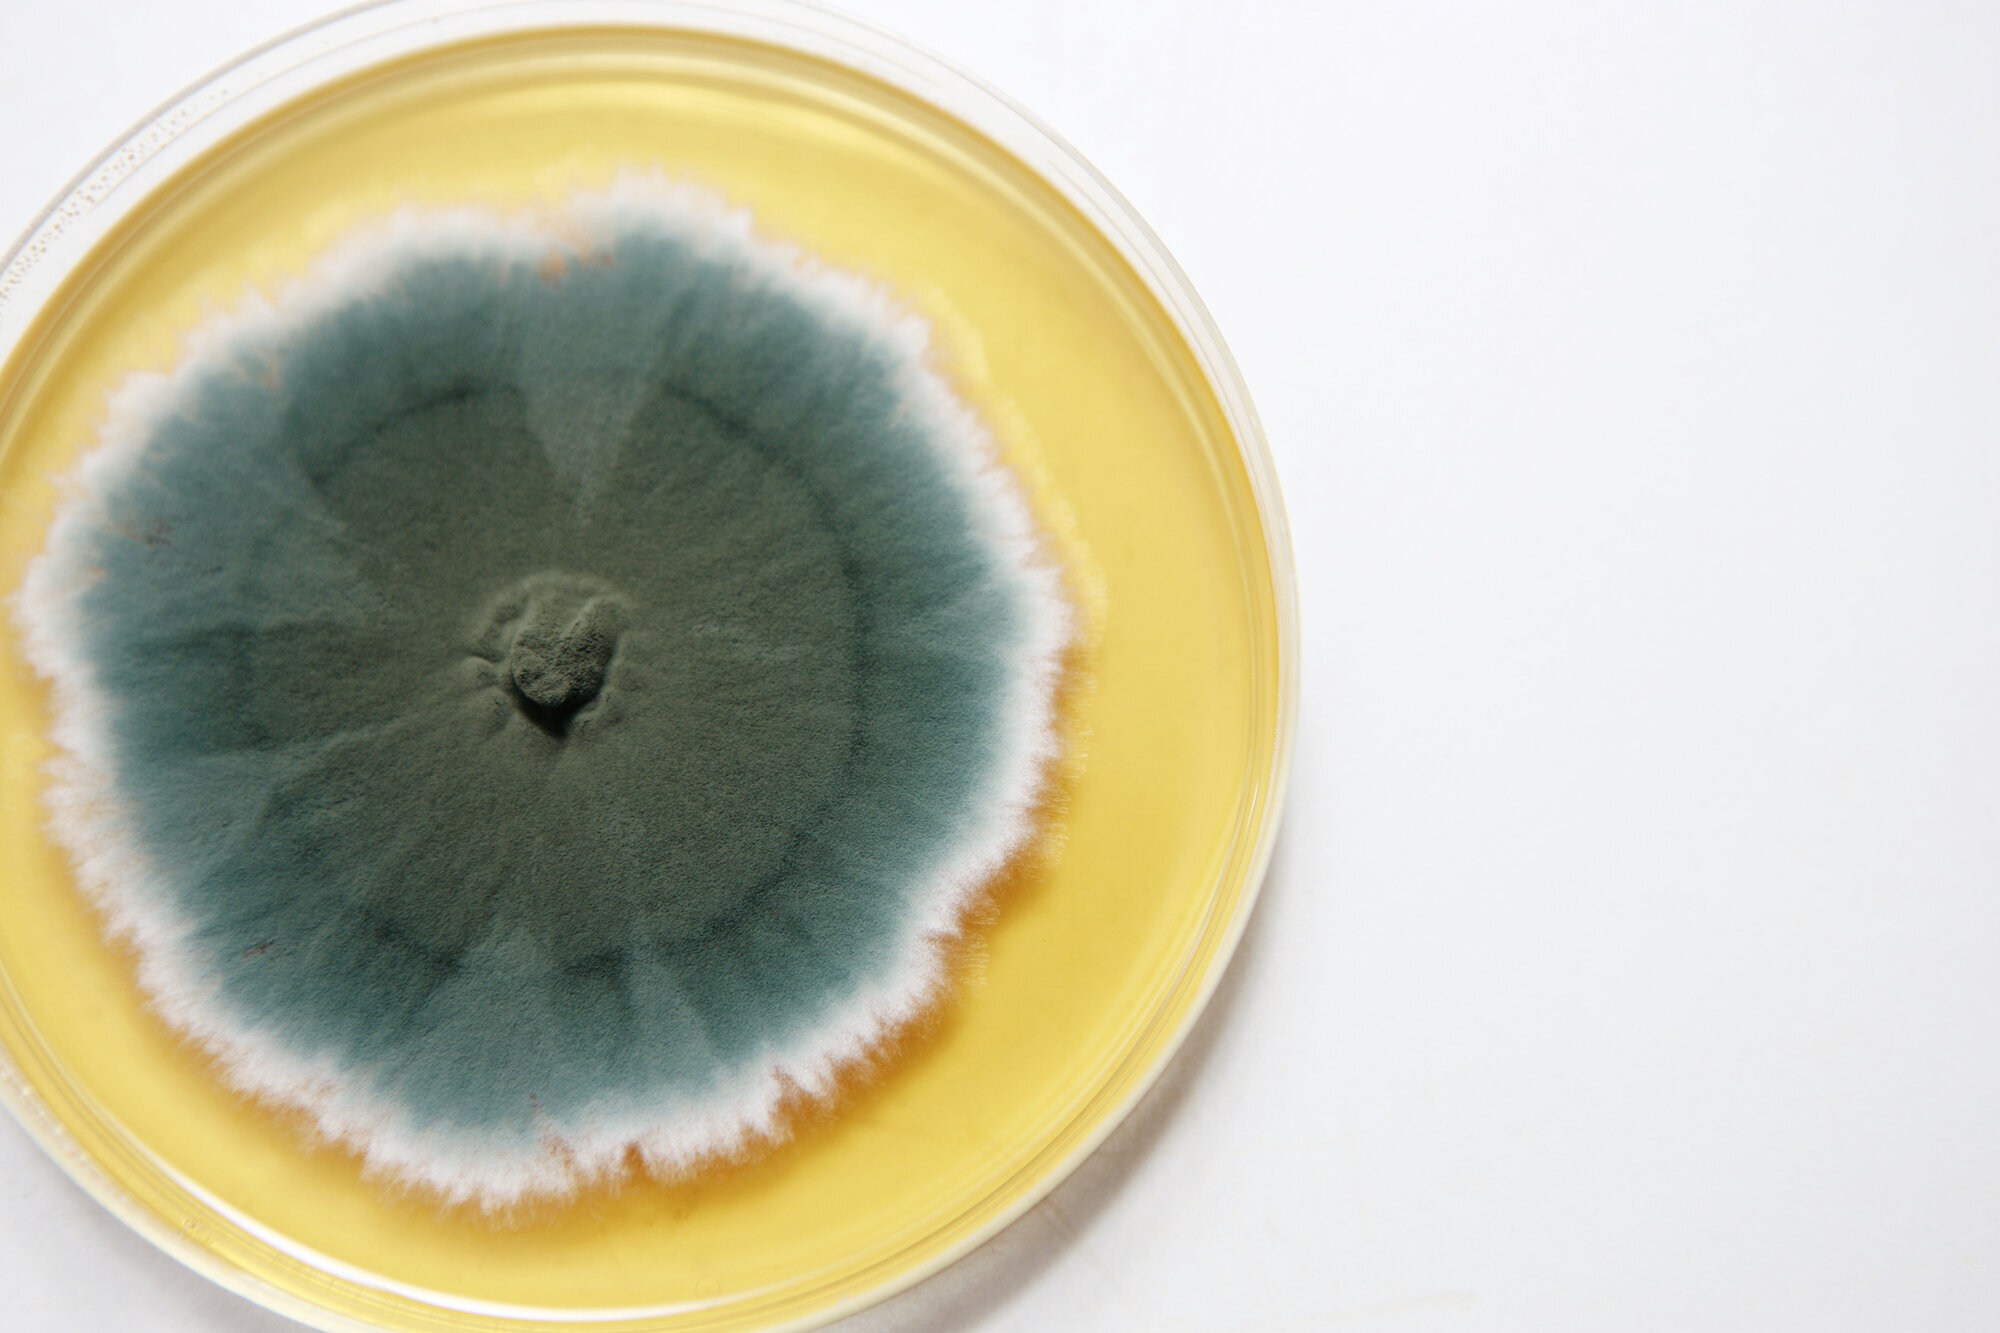
Bildet viser en petriskål med penicillin.

Antibiotika: Mirakelets tid er nesten forbi

Uvettig bruk av antibiotika truer hele den moderne medisinen. Sykepleiere kan gjøre en forskjell.
En gang var penicillin vidundermedisinen som kunne kurere alt. Nå vet vi at penicillin og andre antibiotika har begrenset levetid og skal brukes med varsomhet. Skrekken er at de en dag ikke lenger virker.
Advarte tidlig
Alexander Fleming, som i 1928 ved en tilfeldighet oppdaget penicillinet, advarte allerede i 1945 mot at bakteriene hadde et mottrekk på lur: Evnen til å utvikle resistens, eller motstand, mot vidundermedisinen.
Etterlengtet mirakel
Men tatt i bruk i 1941, i en verden som hungret etter gode nyheter, fikk penicillinet rollen som mirakel. «Thanks to penicillin … He will come home», står det på en reklameplakat fra 1944 som viser en syk soldat som får behandling i felt.
Viktige fremskritt
Penicillin og andre antibiotika som ble utviklet i 1940-, 1950 og 1960-årene utrettet også mirakler. Mange av fremskrittene innenfor moderne medisin, som kreftbehandling, implantatkirurgi og transplantasjoner ville ikke vært mulig uten effektive antibiotika som forebygger og behandler infeksjoner.
Miraklene skjer også i dag.
– Gleden ved å jobbe her er jo å se kjempesyke pasienter bli friske, ofte nettopp på grunn av antibiotika.
Det sier Lene Lunde, fagutviklingssykepleier på infeksjonsavdelingen på Bærum sykehus. Men hun ser også baksiden av medaljen: Bakteriene som antibiotika ikke lenger biter på.
VRE-utbrudd
For antibiotika er både velbrukt og misbrukt. Og jo mer antibiotika som brukes og brukes feil, jo mer resistente blir bakteriene.
MRSA, eller meticillinresistente gule stafylokokker, er allerede en hyppig gjest på norske sykehus. Men også VRE (vankomycinresistente enterokokker) og ESBL (extended spectrum betalaktamase) skaper hodebry for norske leger og sykepleiere. Her på Bærum puster de lettet ut etter et VRE-utbrudd som har pågått siden januar.
– 15. juli var det 3 måneder siden siste positive prøve, og dermed er utbruddet erklært over, sier Lene Lunde og smiler.
Vant til resistens
Men vi skal bare noen dører lenger ned i korridoren for å finne resistens. «Isolering pågår» står det på skiltet utenfor ett av de 8 isolatene. Her er det spørsmål om resistent tuberkulose.
Lunde har jobbet på infeksjonsavdeling siden 2001.
– Vi så antibiotikaresistens den gangen også, men ikke på samme måte som i dag. «Alle» kjente til MRSA, men i 2008–2009 fikk vi også ESBL. Nå er resistens en del av hverdagen.

Redde sykepleiere
I 2013 tok Lunde master i sykepleievitenskap ved å undersøke sykepleieres kunnskap om antibiotikaresistens. Hun hadde erfart at resistente bakterier skaper frykt.
– Jeg synes det var fascinerende med alle sykepleierne som er redde for resistente bakterier, samtidig som det er så enkelt å beskytte seg mot dem, sier hun.
I studien sammenliknet hun sykepleiere som jobber på infeksjonsavdelinger og sykepleiere som jobber på andre medisinske poster. Som ventet (og håpet) fant hun at sykepleierne på infeksjon hadde mer kunnskap enn de andre sykepleierne. 8 av 10 sykepleiere på infeksjon hadde tilstrekkelig kunnskap, mot 6 av 10 på andre medisinske poster. Det vil også si at 2 av 10 på infeksjonsposter og 4 av 10 på andre medisinske poster ikke hadde tilstrekkelig kunnskap. Selv om resistente bakterier er noe alle sykepleiere må være forberedt på å møte.
– Det overrasket meg ikke. Jeg er mye rundt og underviser, og får mange spørsmål, sier Lunde.
– Men jeg hadde håpet vi var bedre. Det overrasker meg fortsatt at det er sykepleiere som ikke skjønner at man må droppe ringer på jobb.
Mangler kunnskap
For mens resistens er en relativt ny problemstilling, er mottiltakene gamle.
– Det handler om basalt smittevern. Om å utføre riktig håndhygiene, vite hvor man har hendene og å skape barrierer, påpeker Lunde.
– Resistens i seg selv er et stort problem, men å håndtere det er ikke vanskelig.
Hovedfunnet i masteren hennes er at de fleste sykepleierne vet hva slags smittevernutstyr de skal bruke, men de vet ikke hvorfor. Under halvparten kjente til hvordan MRSA smitter. Enda færre kjente til smittemåten for ESBL.
– MRSA smitter ved kontakt. Det er ikke sånn at bakteriene står i døren og venter på deg. De flyr ikke, de angriper ikke. Vet vi hvordan bakteriene oppfører seg, er det lett å håndtere dem.

Sykepleiernes rolle
Studien hennes er liten og kunne med fordel repeteres i større skala. Lunde selv vil gjerne gå videre til doktorgrad og undersøke sykepleieres rolle i jobben med antibiotikaresistente bakterier. Hun sier det ikke er gjort noe på dette i Norge, men sliter med å få støtte.
Planen hennes er å se hvilken rolle sykepleierne spiller i bruken av antibiotika. For smittevern er ikke nok i kampen mot resistens. Aller viktigst er det å redusere bruken av antibiotika. Jo mer antibiotika som brukes, jo bedre kjent blir bakteriene med stoffene, og det blir lettere for dem å utvikle resistens.
Over til tabletter
– Legene skriver ut antibiotika, understreker Lunde.
– Men sykepleierne administrerer dem, vi tar imot prøvesvar og vi observerer pasienten. Det er viktig å formidle de rette observasjonene. Informere om prøvesvar som kanskje viser at pasienten kan gå over til et mer smalspektret antibiotikum. Dokumentere klinisk tilstand, som kanskje tilsier at pasienten kan gå over fra intravenøs behandling til tabletter, som gir mindre risiko for resistens. Det krever at vi bruker det kliniske blikket, tar temperatur, puls, blodtrykk ofte og ikke minst at vi snakker med pasienten selv. Og så må vi videreformidle til legen. Forteller vi ikke hva vi observerer, vet ikke legene det.
Trygge
«Isolat, sluse» står det utenfor et av pasientrommene på infeksjonsposten. Sykepleier Leny Abila tar på seg hansker med raske, vante bevegelser. I begynnelsen kunne hun kjenne på usikkerheten i møte med smittsomme bakterier, resistente eller ikke.
– Da var jeg nøye med å trekke hanskene helt opp til albuene og klemme munnbindet hardt mot nesen.
Nå er hun trygg.
– Det handler om basalt smittevern, sier hun.
– Gode rutiner og god opplæring.
Kollega Silvia Lopez er enig.
– Jeg har aldri syntes smitte har vært skummelt. Jeg vet hvilke prosedyrer jeg skal bruke for å beskytte meg. Fordelen her på infeksjon er at vi vet at pasientene har smittsomme og noen ganger resistente bakterier. Andre poster kan også ha smittsomme pasienter uten at de er klar over det.
Skylleromseksamen
Her på infeksjon har vinterens og vårens VRE-utbrudd også medført noe godt.
– Vi har vasket ned avdelingen, gått gjennom alle rutiner og fått bort korridorpasienter, sier fagutviklingssykepleier Lunde.
– Det var ting vi ikke gjorde bra nok.
De har rettet ekstra oppmerksomhet mot smittevern, avfallshåndtering og skyllerom, og alle pleiere har hatt skylleromseksamen.
– Det ga en ny giv, en enighet om at vi skal være bedre enn dette.
Termometersmitte
Kilden til utbruddet fant de aldri. Men de har en mistanke om hva som kan ha brakt smitten rundt.
Lene Lunde holder frem et rektaltermometer.
– Før brukte vi plasthylse som vi kastet og spritet termometeret etter bruk. Men det er kanskje ikke godt nok. Derfor har nå hver pasient sitt eget termometer. Når de reiser hjem, får de det enten med seg eller det går i søpla.
I tillegg er nå blodtrykksapparat og stetoskop noe som tilhører hvert enkelt rom. Og det er slutt på korridorpasienter.
– Det er takket være VRE-utbruddet, sier Lunde om pålegget fra ledelsen om at det ikke kan være pasienter på korridor eller behandlingsrom på denne avdelingen.
– I 2014 kunne vi ha 25 pasienter, men 16 rom. Det går ikke når flere pasienter må isoleres.
Helsetrussel
Antibiotikumets gullalder er definitivt forbi. Verdens helseorganisasjon sa i 2012 at resistens mot slike medisiner er en av de største helsetruslene verden står overfor. Dessverre var ikke penicillinet mirakelmedisinen som hjelper mot alt. Men det hjelper fremdeles. Håpet er at vi ikke kommer dit at bakterier utvikler resistens mot alle typer antibiotika.
– Og her har sykepleierne en viktig rolle, mener Lene Lunde.
Kilder: Historien om antibiotika av S Yazdankhah, J Lassen, T Midtvedt og C O Solberg, Tidsskrift for Den norske legeforening 23/24-2013, Nasjonal strategi mot antibiotikaresistens 2015-2020, Sykepleie til pasienter med multiresistente bakterier av Lene Lunde, Sykepleien Forskning 3/2014.
Les mer:





















0 Kommentarer